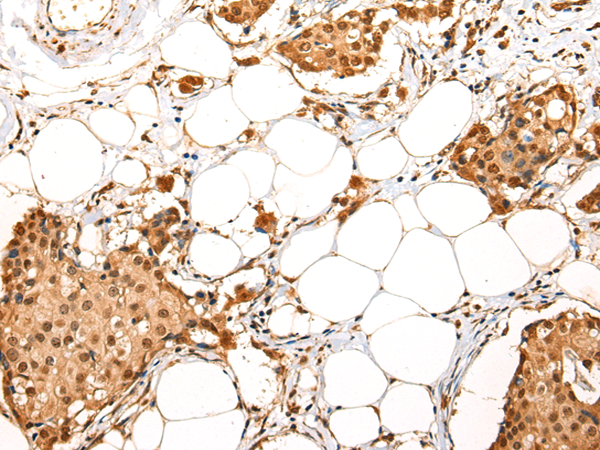

中文名稱:兔抗ADAM19多克隆抗體
|
Background: |
This gene encodes a member of the ADAM (a disintegrin and metalloprotease domain) family. Members of this family are membrane-anchored proteins structurally related to snake venom disintegrins and have been implicated in a variety of biological processes involving cell-cell and cell-matrix interactions, including fertilization, muscle development, and neurogenesis. This member is a type I transmembrane protein and serves as a marker for dendritic cell differentiation. It has been demonstrated to be an active metalloproteinase, which may be involved in normal physiological processes such as cell migration, cell adhesion, cell-cell and cell-matrix interactions, and signal transduction. It is proposed to play a role in pathological processes, such as cancer, inflammatory diseases, renal diseases, and Alzheimer's disease. |
|
Applications: |
ELISA, IHC |
|
Name of antibody: |
ADAM19 |
|
Immunogen: |
Synthetic peptide of human ADAM19 |
|
Full name: |
ADAM metallopeptidase domain 19 |
|
Synonyms: |
MLTNB; FKSG34; MADDAM |
|
SwissProt: |
Q9H013 |
|
ELISA Recommended dilution: |
2000-5000 |
|
IHC positive control: |
Human breast cancer and human esophagus cancer |
|
IHC Recommend dilution: |
25-100 |

購物車
購物車 幫助
幫助
 021-54845833/15800441009
021-54845833/15800441009
